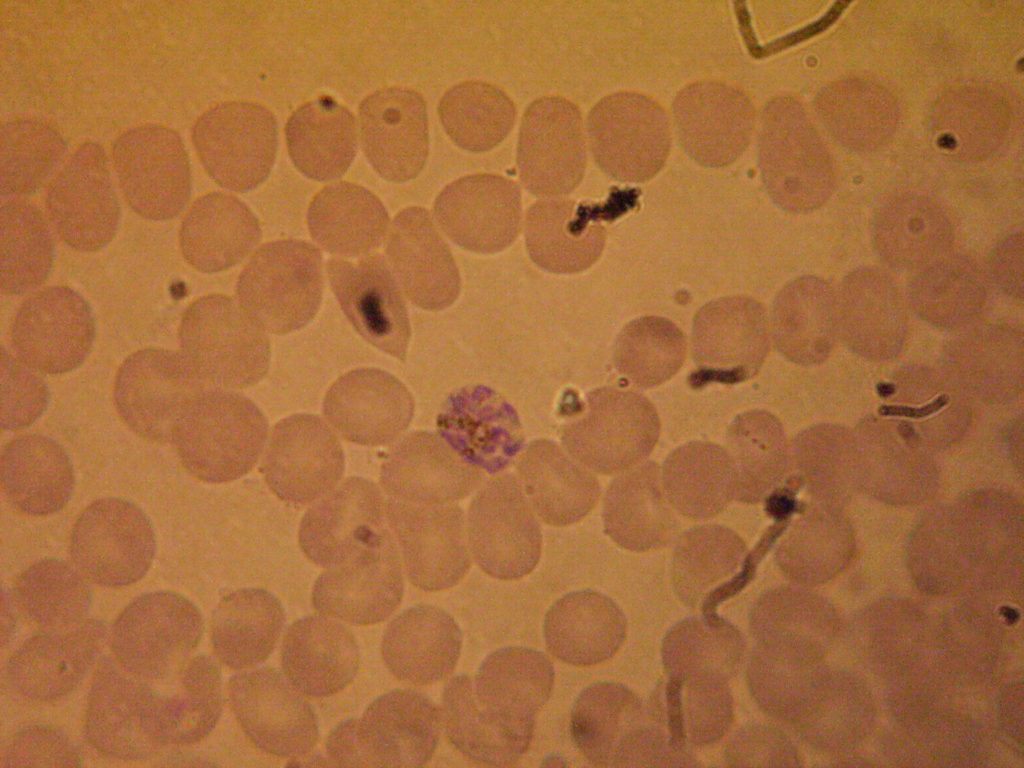

Малярия, которая также известна под названием болотная лихорадка, представляет собой тяжелый недуг с рецедивирующим течением хронического типа.
Фактически это медицинское определение представляет собой ряд инфекционных заболеваний, передающихся через укус самки комаров Anopheles, которые также известны как малярийные. Возбудителем болезни являются паразитические протисты группы Plasmodium.
В течении острой формы заболевания у пациента наблюдаются такие симптомы, как озноб, лихорадка, анемия, увеличение размера селезенки и печени. Особенно тяжело переносят недуг маленькие дети, которым еще не исполнилось и 5 лет.

Областью возникновения и наибольшего распространения малярии считается Африка. Именно на этом континенте ВОЗ фиксирует наибольшее количество заражений. Согласно статистическим данным, ежегодно в мире от болотной лихорадки страдает 124-283 млн. людей.
Но, стоит заметить, что благодаря стремительному развитию медицины, в последнее время число смертей от малярии существенно снизилось и на данный момент составляет около 400 тыс. больных в год.
На территории России болезнь диагностируется преимущественно у прибывших из Африки людей, которые были заражены и не прошли соответствующего лечения.
Ученые активно работают над разработкой вакцины, которая могла бы полностью защитить от болезни. Однако на данный момент удалось добиться лишь возможности эффективной профилактики и результативного лечения.
Поэтому при возникновении малейшего подозрения на болотистую лихорадку следует незамедлительно обращаться в инфекционное отделение и в случае подтверждения диагноза приступать к интенсивной терапии.
Содержание
Патогенез заболевания
Главным возбудителем тропической малярии принято считать простейшие микроорганизмы из биологического рода Plasmodium. Инфицирование организма зачастую происходит в процессе впрыскивания в состав крови или лимфы спорозоитов.
В бытовой ситуации такая процедура происходит при укусе самки малярийного комара. Это явление можно наблюдать непосредственно в тот момент, когда насекомое сосет кровь из организма жертвы.

После попадания в человеческий организм, плазмодия постепенно пробирается к гепатоцитам печени. Это явление приводит к началу доклинической стадии заболевания. Спорозоиты активно размножаются в печеночных клетках, что приводит к формированию мерозоитов, которые спустя лишь несколько месяцев вновь попадают в кровь.
Если заболевание было спровоцировано возбудителями группы P.falciparum или P.malariae, то печеночная стадия болезни завершается достаточно быстро. Когда возбудителем служили другие микроорганизмы, в печени могут оставаться спящие гипнозоиды. Их выход кровь приводит к рецидиву болезни спустя недели, месяцы и даже несколько лет после произошедшего заражения.
Дальнейшей стадией болезни является эритроцитарная (клиническая). Этот этап заболевания начинается с попадания в кровь мерозоитов, которые не только распространяются по организму, но и прикрепляются к эритроцитам и постепенно приводят к их разрушению.
Возникновение и развитие малярии включает следующие этапы:
- плазмодий проникает в состав крови после укуса маткой комара;
- паразитарные микробы проникают в печень, где происходит их интенсивное размножение в максимально благоприятной среде;
- разрушение эритроцитов и нарушение состава крови;
- развитие у зараженного человека признаков лихорадки.
При исследовании болезни, ученые пришли к выводу, что проникая в человеческий организм возбудители активно стимулируют формирование веществ, привлекающих маток комара.
Разновидности болезни
Современные инфекционисты выделяют несколько основных разновидностей малярии. Основное отличие форм болезни между собой заключается не только в типе возбудителя, но также в проявляющихся признаках, течении и медицинском прогнозе.

Возбудителем малярии обычно выступает один из следующих микроорганизмов:
- Plasmodium malariae – возбудитель приводит к возникновению четырех фазной малярии. Инкубационный период при рассматриваемом виде болезни составляет приблизительно 3-6 недель. Обычно наблюдается периодичность приступов не чаще раза в 2 суток.
- Plasmodium ovale — основной возбудитель болотной лихорадки овале. Продолжительность периода проявления первых симптомов при этой форме болезни составляет 10-20 суток. Приступы лихорадки у пациентов могут наблюдаться примерно раз в сутки.
- Plasmodium vivax – приводит к появлению малярии трехдневной. Продолжительность среднего периода инкубации для пациентов с таким диагнозом составляет 1-3 недели, но в некоторых случаях может длиться больше года. Приступы ухудшения самочувствия происходят примерно раз в сутки. Рассматриваемый возбудитель болезни относится к самым популярным.
- Plasmodium falciparum – приводит к возникновению тропической малярии. Инкубационный периода для больных составляет от 9 до 16 суток.
Последний вид болезни является наиболее сложным. Он может привести к существенным нарушениям в функционировании мозга, что является причиной развития церебральной формы малярии. Температура тела пациента повышается до критических значений, что сопровождается интенсивными головными болями, а также возможен бред.
Причины возникновения болезни
Малярию или же болотную лихорадку вызывают укусы самки малярийного комара. Однако, стоит помнить, что болезнь передается не только через укус насекомого. Также врачи выделяют следующие пути возможного заражения:
- во время беременности;
- при переливании крови;
- проведение инъекций одним шприцом.
Однако основным и наиболее вероятным путем инфицирования является все же укус комара. Поэтому в группе риска находятся туристы, желающие посетить Африканский континент и страны с высокими показателями заболеваемости.
Симптоматика малярии
Основные признаки малярии проявляются не сразу, а через некоторое время после факта заражения. Инкубационный период в зависимости от типа возбудителя может составлять от недели до месяца. При развитии малярии человек может столкнуться с достаточно тяжелыми симптомами:
- температура, вызывающая озноб или лихорадку;
- ломота и ноющие ощущения в суставах;
- сильная головная боль;
- гипертрофия внутренних органов;
- тошнота, часто приводящая к рвоте;
- расстройство кишечника;
- повышенная потливость;
- понижение гемоглобина;
- чувство усталости, слабость.
Малярия может протекать с дополнительными проявлениями в виде покалывания кожи, высыпаниями и нарушением мочеиспускания. Вероятно возникновение дисфункции сердечно-сосудистой системы.
Особенности диагностики
Если обратившегося за помощью пациента, без видимых на то причин, беспокоят периодические приступы озноба и лихорадки, то обязательно стоит исключить малярию. С помощью лабораторного исследования крови возможно обнаружение возбудителя болезни.

При малярии характерными признаками будут существенные изменения состава крови. Если болезнь протекает в человеческом организме на протяжении долгого времени, то отмечаются высокие показатели СОЭ.
Также одной из основных задач лабораторного исследования крови является определение типа возбудителя. Эта задача решается путем проведения быстрых диагностических текстов, микроскопического исследования и серологической диагностики.
Современные методики лечения
Терапия малярии производится исключительно в стационарных условиях и под постоянным наблюдением специалистов. Согласно наблюдениям ученых, современные возбудители болезни выработали резистентность к некоторым видам антибиотиков. Поэтому крайне важное значение имеет составление правильного курса лечения и применение эффективных медикаментозных средств.
Основная цель терапии заключается в купирования острых приступов заболевания, предупреждение осложнений и патологических процессов. Также одной из основных задач медиков является предотвращение рецидивирующего течения болезни.
При первых проявлениях заболевания важно срочно обратиться к специалистам. Побывавшим в зоне повышенного риска заражения людям реагировать на возникновение лихорадки необходимо максимально быстро. ебанулась катализирует в инфекционном отделении стационара и подтверждение диагноза назначается применение хлорохина, делагила, хингамина и т.д.

Уже на этапе лечения малярии стоит проводить комплекс реабилитационных мероприятий, которые помогут добиться активного восстановления организма.
Какие существуют профилактические меры?
В основе профилактики малярии лежит предотвращение укусов комаров. Вакцина от инфекционного заболевания находятся лишь в разработке ученых. Клинические испытания имеющихся препаратов для вакцинации показали эффективность результата на уровне не более 56%, чего недостаточно для запуска в массовое производство и распространение.
Единственно возможным методом химической профилактики заболеваний являются таблетки. Прием специализированных препаратов стоит начинать за несколько недель до посещения потенциально опасных стран.

Профилактические препараты от малярии назначаются врачом-инфекционистом индивидуально. Решение по выбору препарата принимаются на основе заключение про здоровье человека и особенностях страны, куда он собирается отправиться.
Среди альтернативных способов профилактики малярии можно выделить следующие:
- регулярная обработка помещений при помощи инсектицидов, задача которых заключается в уничтожении комаров и других насекомых;
- применение специальных защитных сеток, предназначающихся для сна за пределами помещения;
- ношение закрытой одежды и обработка открытых участков кожи специальными кремами и спреями — репеллентами.
Находясь в опасных зонах важно соблюдать все перечисленные методы профилактики.
Возможные последствия
При отсутствии комплексного и своевременного лечения болезни ее течение может продолжаться на протяжении нескольких лет. К наиболее распространенным последствиям перенесенного инфекционного заболевания можно отнести нарушения в работе внутренних органов, поражение ЦНС, а также продолжительную потерю трудоспособности.
Среди наиболее опасных для жизни человека осложнений тропической малярии можно выделить следующее:
- разрыв селезенки;
- малярийная кома;
- гемоглобинурийная лихорадка;
- нарушения в функционировании почек;
- психоз.
При развитии у больного малярийной комы, пациент впадает в длительный сон вывести из которого его практически невозможно. При этом наблюдаются недержание мочи и кала, а также судорожные припадки.

Основным признаком разрыва селезенки является острая боль в области живота, наличие опухоли в районе левого подреберья и обморок. При подобных симптомах требуется срочное хирургическое вмешательство.
Наиболее распространенным осложнением тропической лихорадки является церебральная малярия. Такое состояние имеет три основные стадии. Сомолентная характеризуется относительно легким проявлением симптоматики, наиболее значимыми признаками болезни при которой считаются головные боли, боязнь солнечного света, вялость и общая усталость.

В период сопора наблюдается существенное усугубление симптомов к которым добавляются судороги, пересыхание слизистых носоглотки, изменение окраса кожных покровов, также может развиваться тахикардия. Кома — глубокий сон, когда больной не реагирует на раздражители. Каждое из перечисленных осложнений болезни, без должного лечения может привести к смерти пациента.
Прогноз
Прогноз лечения малярии зависит от разновидности болезни и особенностей ее течения. Развитый уровень медиции при своевременном обращении к специалистам позволяет дать вполне благоприятный прогноз терапии. Однако развитие осложнений может стать причиной летального исхода. В основной группе риска находятся беременные женщины и дети.
